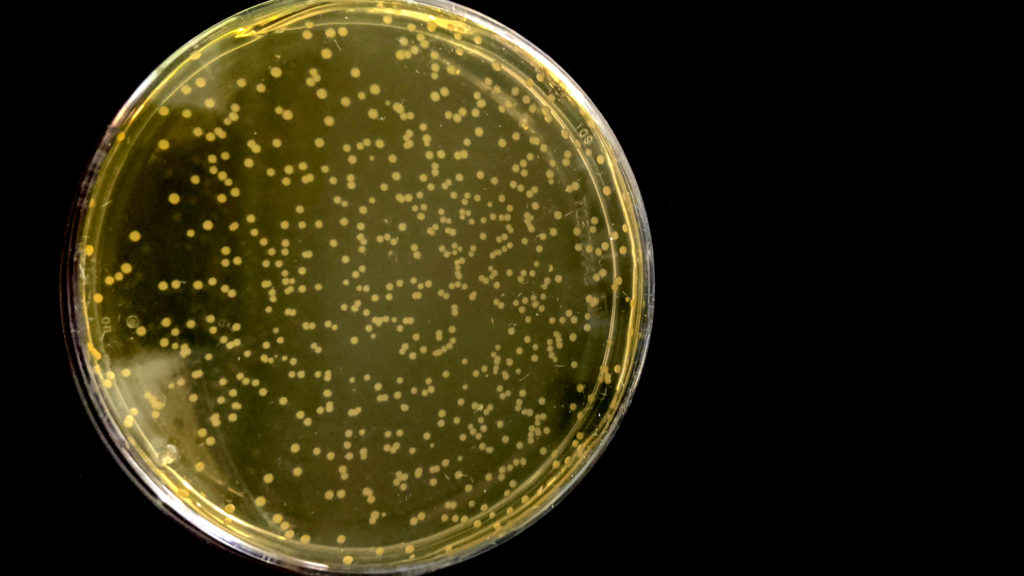

A,T,G,C 四种碱基能够排列出64种密码子进行蛋白质合成, 是构成生物的基础。 不久之前,科学家们对自然界沿用了几十亿年的遗传密码做了历史性的重新编写。
“重新编码”基因组的大肠杆菌,在琼脂平板上生长。
在伦敦郊外Jason Chin的实验室中,一群大肠杆菌在撒有营养的肉汤的塑料小盘子里快乐地吃喝、幸福地繁殖、自由地呼吸着,它们看上去很普通。但它们与地球上的其他生物有着本质的不同。科学家们对这群大肠杆菌的基因进行了重新编辑,获得了有史以来最广泛的“重新编码”基因组。

Jason Chin 图片来源:MRC分子生物学实验室
英国剑桥MRC分子生物学实验室的Jason Chin教授与其同事重新编码了一个大肠杆菌菌株的全部基因组,只用59个密码子就合成出所有的必需氨基酸。该研究近日发表在《Nature》杂志上。哈佛大学生物学家George Church评价说:“这是一个重大的里程碑。”

DOI: 10.1038/s41586-019-1192-5
自然界的密码本

众所周知,虽然自然生物拥有着不同的形态特征,但生物遗传信息却是由同一套的DNA遗传密码来传递的。组成DNA的核苷酸含有A、T、G、C四种碱基,每含有三个碱基的核苷酸构成一个“密码子”编写一个特定的氨基酸。 排列出64种密码子构成生物的基础。然而一种氨基酸对应的密码子不止一个,如果冗余的同义密码子可以得到替换,那么天然蛋白质的合成就可以通过替换生物体内“多余”密码子来实现。
有史以来最大的基因组合成

Jason Chin教授与其同事创造了一个4M字节的合成基因组的大肠杆菌变种。合成基因组优化和重构了编码方案:只需在七个位置进行简单的修正就可以替换基因组中所有已知的两个有意密码子和一个终止密码子。研究人员重新编码了18214个密码子,创造了一个拥有61个密码子基因组的生物体。这种生物使用59个密码子来编码20种基本氨基酸,并能够删除以前必不可少的核糖体RNA (tRNA)。
如何重新编码?
就像是平时在全文里把特定词组替换成同义词一样,生物体基因组的重新编码也是如此。鉴于生物基因组中拥有庞大的碱基对,为了实现高效替换,科学家们采用了一种巧妙的拆解和替换方法。
他们先把大肠杆菌分解为长度10kb左右的小片段。接着找出基因组开放阅读框中的TAG密码子,全部替换为同样表达终止的TAA(一般而言TAA、TAG和TGA都代表终止信号)。在编码必需氨基酸时,用AGC替换了每一个编码丝氨酸密码子TCG,用AGT替换了每一个TCA (同样编码丝氨酸)。
Chin把改编过的大肠杆菌称为“Syn61”,因为这些细菌中的三个目标密码子全部被同义密码子取代仅,使用了61个密码子。伦敦帝国理工学院合成生物学专家Tom Ellis在审阅完这篇论文说:“他们创造了一种不使用自然界其他三种密码子的菌株。在未用到全部生物模块的情况下,生命依旧存在。”
值得注意的是,重新编码的基因组可能不受病毒影响。正如George Church所说,Syn61可能不受病毒影响。从制药到食品,每年因病毒感染而造成的工业损失达到数百万美元,重新编码细菌基因组则有望大大降低这一损失。
参考资料:
[1] Total synthesis of Escherichia coli with a recoded genome
[2] With a ‘recoded’ bacteria genome made from scratch, scientists give life a new dictionary
四川省医药保化品质量管理协会召开第七
2026年6月8日,四川省医药保化品质..关于召开第七届九次理事会暨会长办公会
各相关单位: 经研究,四川省医..四川省医药保化品质量管理协会举办2026
当前,制药行业正处于合规升级与绿..关于举办四川省药品生产企业拟新任质量
各相关企业: 新修订的《中华人..四川省医药保化品质量管理协会党支部
2026年4月8日上午,省医药保化品质..四川省医药保化品质量管理协会党支部
2026年4月8日上午,省医药保化品质..四川省医药保化品质量管理协会党支部召
按照省市场监督管理局社会组织联合..120亿美元押中!诺华AOC临床告捷
6月11日,诺华宣布其针对面肩肱型..